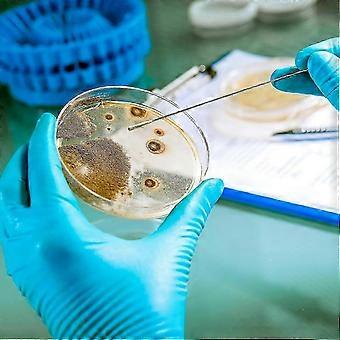
product image

10 db előregyártott agar tányér csomag 7 cm-es Petri-csészék tudományos kísérletekhez és STEM oktatáshoz
+ 3 549,00 Ft szállítási költség

10 db előregyártott agar tányér csomag 7 cm-es Petri-csészék tudományos kísérletekhez és STEM oktatáshoz
- Márka: Unbranded
10 db előregyártott agar tányér csomag 7 cm-es Petri-csészék tudományos kísérletekhez és STEM oktatáshoz
- Márka: Unbranded
Megtakarítás 10 800,00 Ft (45%)
RRP
14 napos visszaküldési szabályzat
Megtakarítás 10 800,00 Ft (45%)
RRP
14 napos visszaküldési szabályzat
Fizetési módok:
Leírás
10 db előregyártott agar tányér csomag 7 cm-es Petri-csészék tudományos kísérletekhez és STEM oktatáshoz
- Márka: Unbranded
- Kategória: Petri csészék
- Fruugo azonosító: 436941310-915757267
- EAN: 9001457141637
Kiszállítás és visszaküldés
Kiküldés 2 napon belül
-
STANDARD: 3 549,00 Ft - közötti szállítás K 06 január 2026–H 12 január 2026
Szállítás innen: Kína.
Minden tőlünk telhetőt megteszünk annak biztosítására, hogy rendelését hiánytalanul és előírásainknak megfelelően szállítás ki önnek. Viszont ha egy hiányos rendelést kap, vagy eltér a megrendelttől, vagy bármilyen más okból nem elégedett a rendeléssel, akkor visszaküldheti a rendelést vagy a rendelésben lévő bármely terméket, és visszatérítik a termék árának teljes összegét. Teljes visszaküldési irányelvek megtekintése.
Termékmegfelelőségi részletek
Kérjük, tekintse meg a termékre vonatkozó megfelelőségi információkat az alábbiakban.
Az alábbi információkat a terméket értékesítő független, harmadik fél kiskereskedő biztosítja.
Gyártó:
Az alábbiakban olvashatók a Fruugo platformján értékesített releváns termék gyártójának elérhetőségei.
- Rogue & Refine
- Foshan Shini Diao Trading Co., LTD
- Room 105, No. 75, Guidan West Road, Laobian Community, Danzao Town, Nanhai District, Foshan City, Guangdong Province
- Foshan
- CN
- 528200
- uidnajsalf@163.com
- 18275827258
Felelős személy az EU-ban:
Az alábbiakban olvashatók az Európai Unióban kijelölt felelős személy elérhetőségei. A felelős személy az az Európai Unióban székhellyel rendelkező gazdasági társaság, amely az Európai Unióban eladott releváns termékekhez kapcsolódó megfelelőségi kötelezettségekért felel.
- Jean Luc
- In Memoria Futuri SAS
- 3 RUE DU PAS DE LA MULE 75004 PARIS
- Paris
- France
- 75004
- infoapexchen@gmail.com
- 33745713901